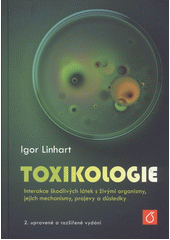

oprava existující anotace, přidání nové anotace
|
Název: |
| Toxikologie: interakce škodlivých látek s živými organismy, jejich mechanismy, projevy a důsledky |
Autor: |
| Linhart, Igor |
Rok vydání: |
| 2014 |
Identifikátory: |
| 9788070808771 cnb002611975 (OCoLC)890262304 |
|
© 2013-2026 Obálkyknih.cz - Jihočeská vědecká knihovna v Českých Budějovicích, admin@obalkyknih.cz